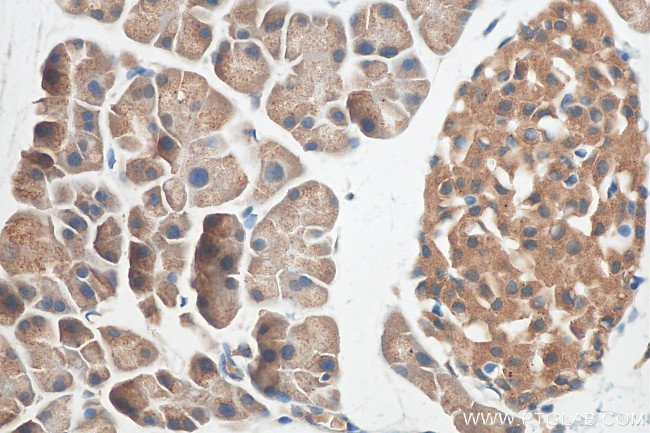
SEC16A Antibody in Immunohistochemistry (Paraffin) (IHC (P))

Search
Proteintech
SEC16A Polyclonal Antibody
{{$productOrderCtrl.translations['antibody.pdp.commerceCard.promotion.promotions']}}
{{$productOrderCtrl.translations['antibody.pdp.commerceCard.promotion.viewpromo']}}
{{$productOrderCtrl.translations['antibody.pdp.commerceCard.promotion.promocode']}}: {{promo.promoCode}} {{promo.promoTitle}} {{promo.promoDescription}}. {{$productOrderCtrl.translations['antibody.pdp.commerceCard.promotion.learnmore']}}
产品信息
29417-1-AP
种属反应
宿主/亚型
分类
类型
抗原
偶联物
形式
纯化类型
保存液
内含物
保存条件
运输条件
产品详细信息
Immunogen sequence: EVGKPEDEAS GSFFKQIDSS PVGGETDETT VSQNYRGSVS QPSTPSPPKP TGIFQTSANS SFEPVKSHLV GVKPFEADRA NVVGEVRETC VRQKQCRPAA ALPDASPGNL EQPPDNMETL CAPQVCPLPL NSTTEAVHML PHAGAPPLDT VYPAPEKRPS ARTQGPVKCE SPA
靶标信息
DNA methylation, or the addition of methyl groups to cytosine bases in the dinucleotide CpG, is imperative to proper development and regulates gene expression. The methylation pattern involves the enzymatic processes of methylation and demethylation. The demethylation enzyme was recently found to be a mammalian protein, which exhibits demethylase activity associated to a methyl-CpG-binding domain (MBD). The enzyme is able to revert methylated cytosine bases to cytosines within the particular dinucleotide sequence mdCpdG by catalyzing the cleaving of the methyl group as methanol. MeCP2 and MBD1 (PCM1) are first found to repress transcription by binding specifically to methylated DNA. MBD2 and MBD4 (also known as MED1) were later found to colocalize with foci of heavily methylated satellite DNA and believed to mediate the biological functions of the methylation signal. Surprisingly, MBD3 does not bind methylated DNA both in vivo and in vitro. MBD1, MBD2, MBD3, and MBD4 are found to be expressed in somatic tissues, but the expression of MBD1 and MBD2 is reduced or absent in embryonic stem cells, which are known to be deficient in MeCP1 activity. MBD4 have homology to bacterial base excision repair DNA N-glycosylases/lyases. In some microsatellite unstable tumors MBD4 is mutated at an exonic polynucleotide tract.
仅用于科研。不用于诊断过程。未经明确授权不得转售。
篇参考文献 (0)
生物信息学
蛋白别名: p250; protein SEC16 homolog A; Protein transport protein Sec16A; SEC16 homolog A; transitional ER site protein; unnamed protein product
基因别名: KIAA0310; p250; SEC16; SEC16A; SEC16L
UniProt ID: (Human) O15027
Entrez Gene ID: (Human) 9919